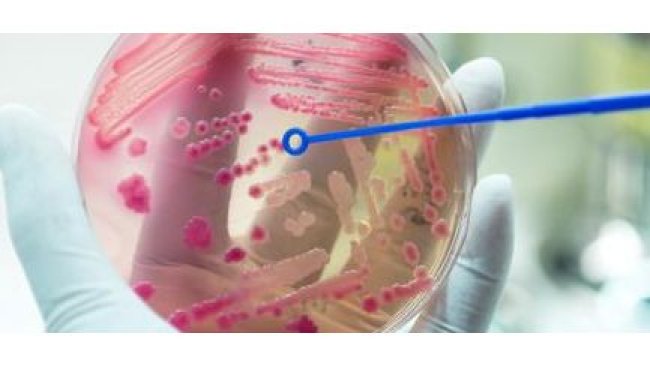
antimicrobial resistance

Strona 6 - artykuły na temat antybiotyk
Właściwości przeciwdrobnoustrojowe olejków eterycznych z drzewa herbacianego i rozmarynu w chłodzonych dawkach nasienia świń
USA: NARMS informuje o oporności na środki przeciwdrobnoustrojowe u świń

Zmiany w przepisywaniu środków przeciwdrobnoustrojowych w UE: pytania i odpowiedzi (II)
Czy obecna kategoryzacja antybiotyków jest ostateczna? Jakie środki podejmą władze w celu poprawy zdrowia świń? Czy lekarz weterynarii może mieć jakiekolwiek problemy, jeśli po postawieniu diagnozy zastosuje antybiotyk z grupy B?
UK: spadek stosowania antybiotyków u świń i oporności bakterii
Chiny zaostrzają przepisy dotyczące pozostałości leków weterynaryjnych
Dania: oporność na antybiotyki u zwierząt gospodarskich i w mięsie

Zmiany w przepisywaniu środków przeciwdrobnoustrojowych w UE: pytania i odpowiedzi (I)
Czy lekarz weterynarii powinien leczyć chore zwierzęta, niezależnie od okoliczności i warunków, które sprzyjały pojawieniu się choroby? Profilaktyka czy metafilaktyka?
Kraje europejskie nadal ograniczają stosowanie antybiotyków u zwierząt
Związek między stosowaniem środków przeciwdrobnoustrojowych, środkami bezpieczeństwa biologicznego, a wydajnością gospodarstwa
Wpływ podawania środków przeciwdrobnoustrojowych po urodzeniu na występowanie genów oporności na środki przeciwdrobnoustrojowe u prosiąt
Dynamika rezystomu oporności na antybiotyki w odchodach świń odsadzonych po podaniu oksytetracykliny
USA i UE: przemysł farmaceutyczny w dobie odporności na antybiotyki
Obiecujące wyniki sekwencjonowania całego genomu w walce z opornością na antybiotyki
Zastosowanie sekwencjonowania całego genomu może poprawić sposób monitorowania oporności na środki przeciwdrobnoustrojowe (AMR) w żywności i u zwierząt.

OIE: pilne działania w celu zapobieżenia kryzysowi oporności na środki przeciwdrobnoustrojowe
Organizacja Narodów Zjednoczonych, międzynarodowe agencje i eksperci opublikowali dziś przełomowy raport, żądający natychmiastowych, skoordynowanych i ambitnych działań, aby zapobiec potencjalnie katastrofalnemu kryzysowi lekowemu.

Prawidłowe funkcjonowanie jelit: redukcja liczby bakterii patogennych
Niektóre strategie żywieniowe mogą mieć działanie antybakteryjne. Przykładowe modyfikacje zostały opisane w poniższym artykule.